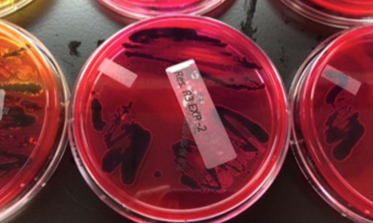

Project Summary
Investigation into the Efficacy of Bdellovibrio bacteriovorus as a Novel Pre‐Harvest Intervention to Control Escherichia coli O157:H7 and Salmonella spp. in Cattle Using an in vitro Model
- Principle Investigator(s):
- Jennifer A. Page, Brian Lubbers, Joshua Mahe, Linda Ritsch, Sara E. Gragg
- Institution(s):
- Kansas State University
- Completion Date:
- August 2014
Background
Salmonella and Escherichia coli O157:H7 are just two of the many pathogens responsible for several foodborne illness outbreaks each year. Cattle commonly harbor these pathogens in their gastrointestinal tracts; thus, these pathogens are capable of contaminating beef products.
Interventions administered to cattle prior to slaughter are aimed at reducing or eliminating pathogen populations within the animal, thereby reducing the opportunity for our beef supply to be contaminated. Bdellovibrio bacteriovorus is a Gram‐negative microorganism that preys upon other Gram‐negative microorganisms, including Salmonella and E. coli O157:H7. Fortunately, B. bacteriovorus is also harmless to human and animal tissues. Given the previously published effectiveness of B. bacteriovorus to reduce Gram‐negative populations, the potential of this microorganism to reduce foodborne pathogen populations warrants investigation.
The objective of this study was to mimic the digestive system of a cow to investigate the effectiveness of Bdellovibrio bacteriovorus to control E. coli O157:H7 and Salmonella populations cattle feces and rumen fluid.
Methodology
Bdellovibrio bacteriovorus was grown per ATCC guidelines to create a stock culture that was stored in a ‐80°C freezer. Fecal and rumen fluid samples were collected from dairy heifers at the Kansas State University dairy unit. The fecal and rumen fluid samples were inoculated with antimicrobial resistant or susceptible strains of E. coli O157:H7 and Salmonella. All experimental samples were mixed with 10 mL of B. bacteriovorus to create a final target concentration of 1.0 x 104 CFU/ml. At 0-, 24-, 48- and 72-hours following inoculation, the samples were analyzed to determine the surviving populations of antimicrobial susceptible and resistant E. coli O157:H7 and Salmonella in cattle rumen fluid and feces.
Findings
Bdellovibrio bacteriovorus was not considered to be effective at reducing antimicrobial resistant or susceptible E. coli O157:H7 populations in cattle rumen fluid or feces. However, as graphs C and D illustrate below, B. bacteriovorus was effective at reducing Salmonella populations in cattle feces in comparison to the control samples. Other studies have shown B. bacteriovorus to be less effective against E. coli O157:H7, as this pathogen produces a compound called indole, which interferes with the ability of B. bacteriovorus to prey upon E. coli O157:H7.
Implications
Reductions in Salmonella populations indicate that B. bacteriovorus may have the potential to inhibit Salmonella survival and growth in cattle. Although these findings are preliminary, the research does suggest promise for B. bacteriovorus as a novel intervention. Future studies are necessary to determine the survivability and effectiveness of B. bacteriovorus throughout the entire digestive system of a cow. Eventually, studies will be required to determine efficacy within a live animal. Using this and future studies as the foundation, the long‐term goal is to develop a novel intervention that will reduce Salmonella populations within the cow and, thus, lead to fewer Salmonellosis outbreaks.

Figure 1. (A) Pansusceptible Salmonella in rumen fluid, (B) Antimicrobial resistant Salmonella in rumen fluid, (C) Pansusceptible Salmonella in feces, and (D) Antimicrobial resistant Salmonella in feces.

Figure 2. Simulation of the cow digestive system with an anaerobic atmosphere, typical cow body temperature and slight shaking to mimic peristaltic motion.

Figure 3. A typical laboratory setup to analyze feces and rumen fluid for Salmonella.
Figure 4. Salmonella growth on petri dishes.